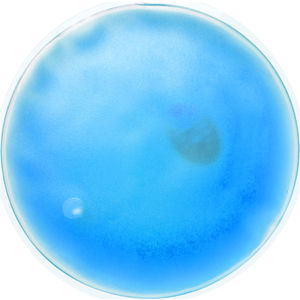

431956 Kison heat pack
Transparent, reusable heat pack with coloured gel.
Dimensions
10mm(w) x 100mm(h)
Colours
Blue, Green, Pink, Red, White, Yellow
Print type and position
PadBack: 50(d)
Front Side: 50(d)
All dimensions are in millimetres
Price breaks and print colour options
Price On Application (POA)
Please contact us for pricing.
All prices are exclusive of Artwork, Origination, VAT & Carriage

!s=300.jpg)
!s=80.jpg)
!s=80.jpg)
!s=80.jpg)
!s=80.jpg)
!s=80.jpg)


